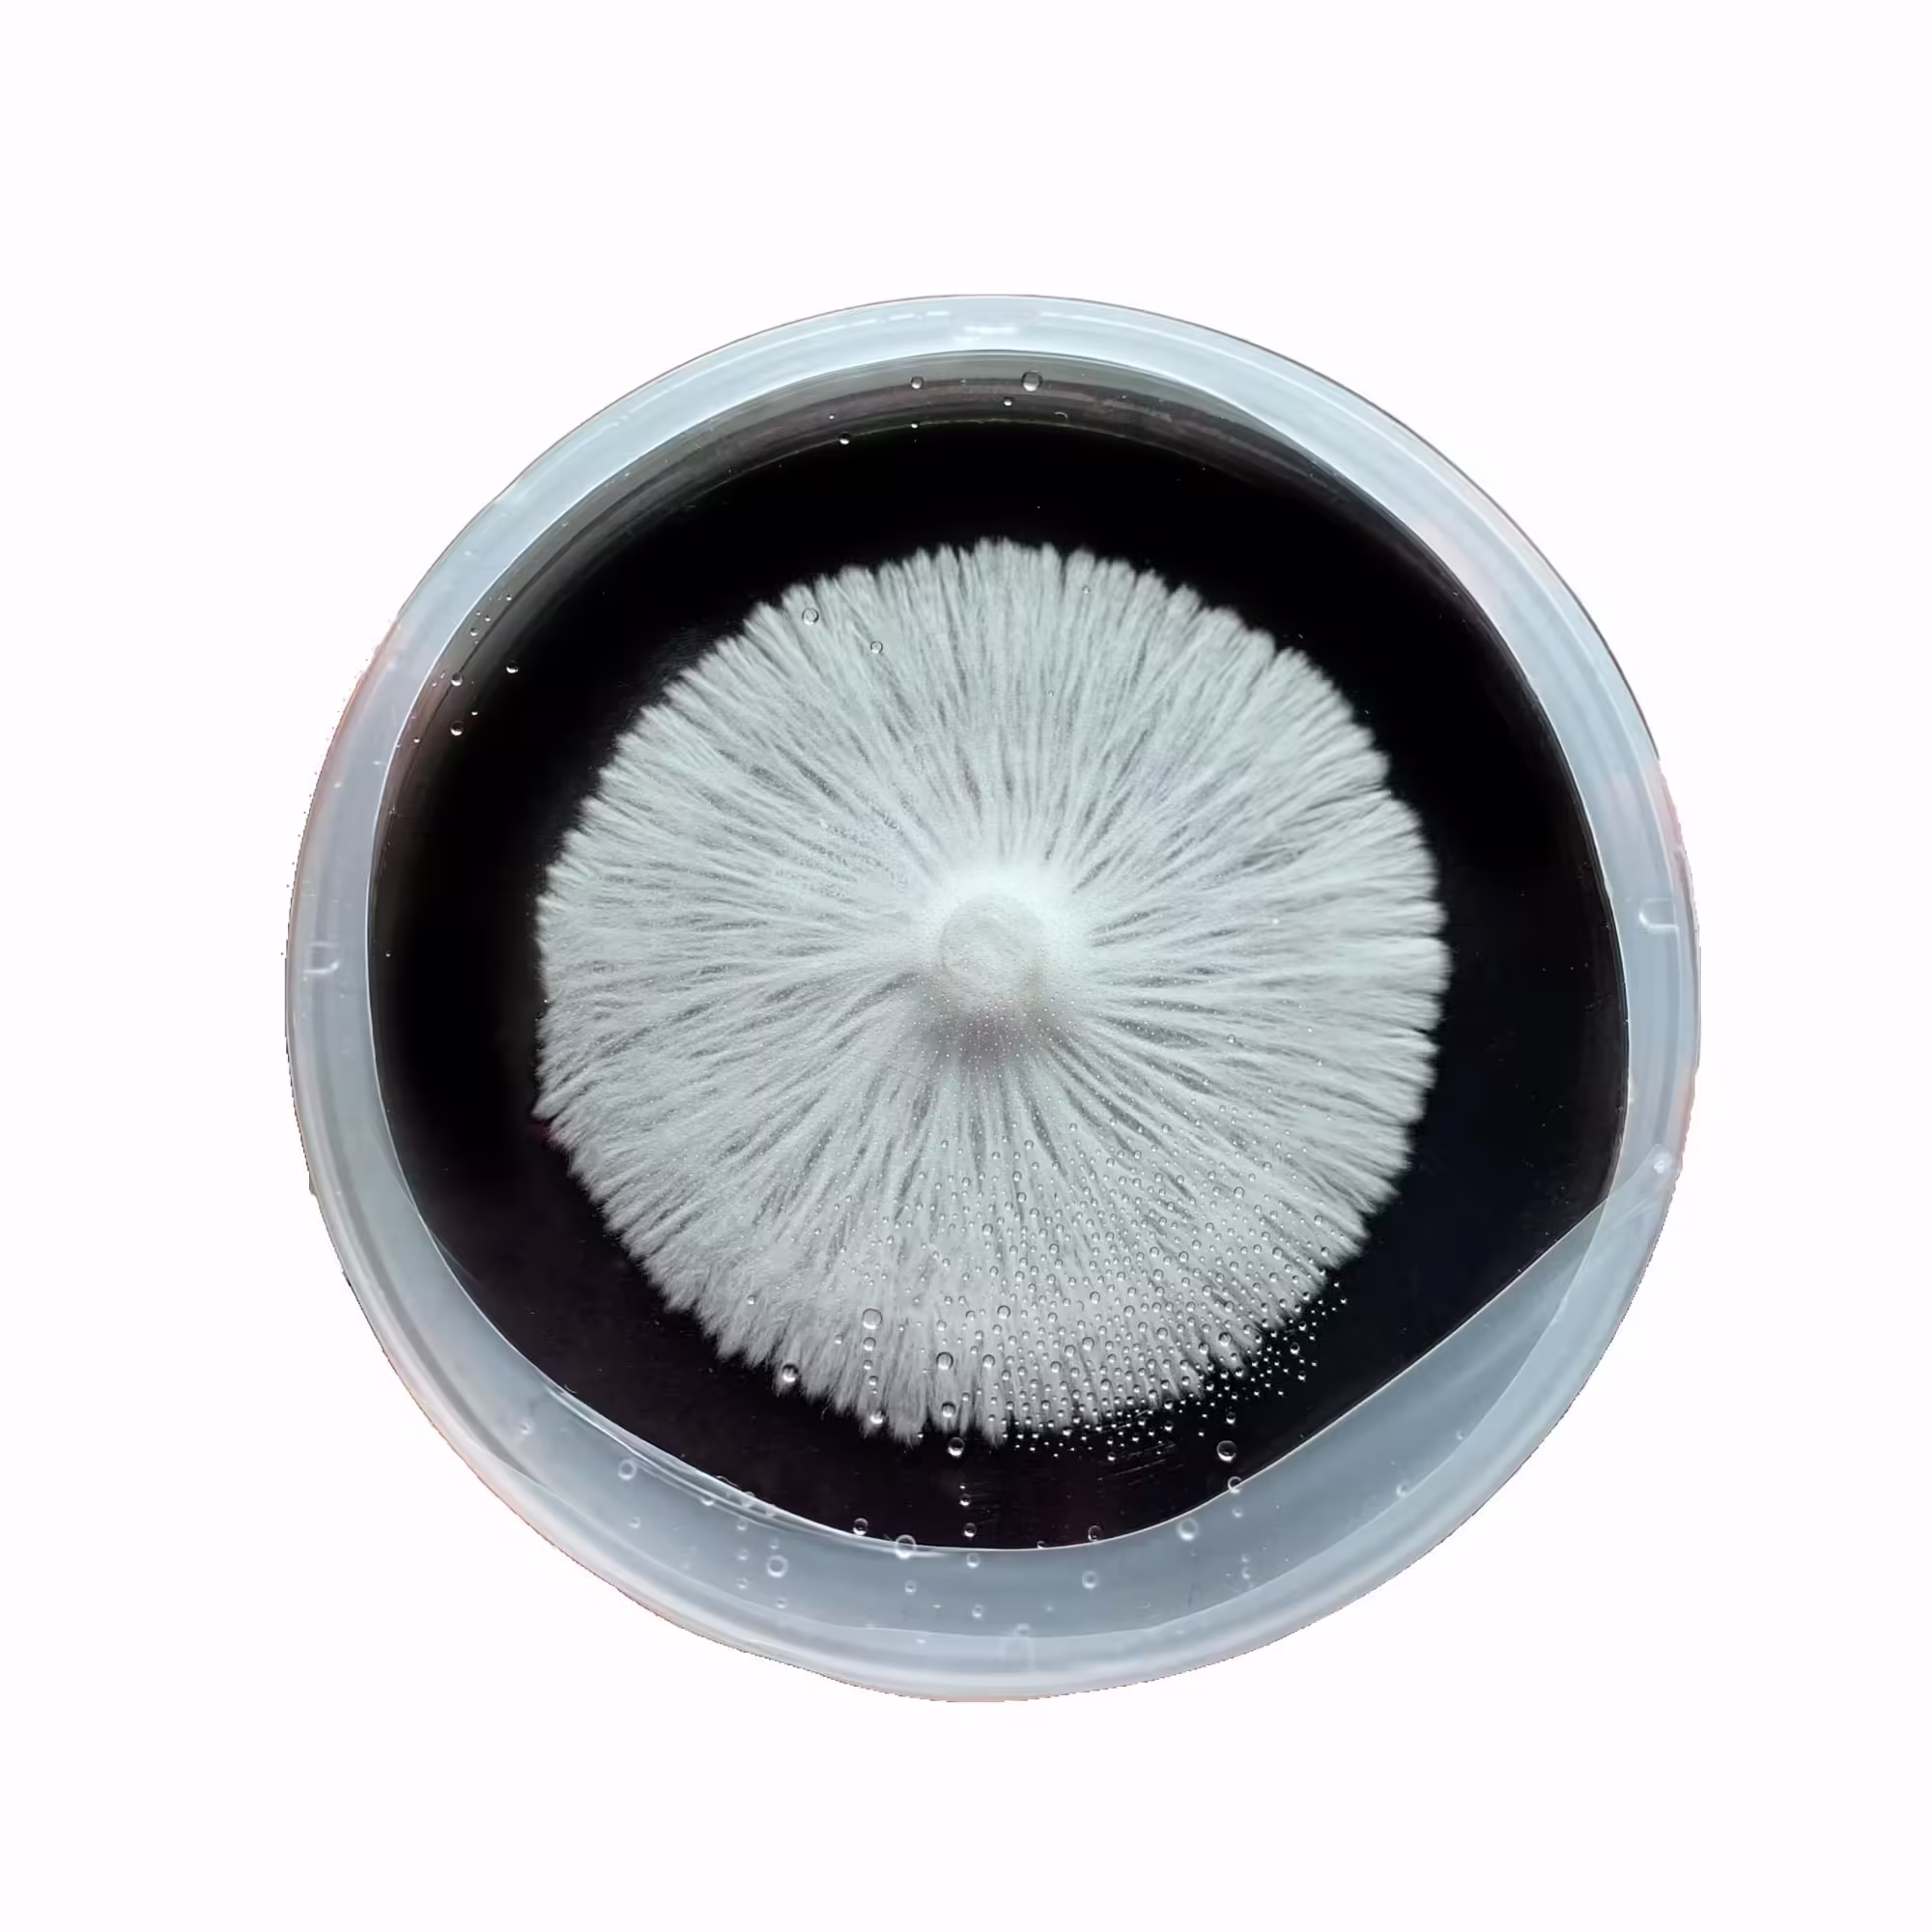

Agar Plates
Agar Plates for Mycology
Our Pre-Poured Agar plates provide a sterile and nutrient-rich environment for spore germination, mycelial growth, and fungal isolation. Each plate is individually sealed to prevent contamination, and we guarantee their cleanliness. Whether you’re a seasoned mycologist or just starting out, our agar plates are a must-have tool for your fungal experiments! 🍄🔬
Free shipping on orders over $100!
- Satisfaction Guaranteed
- Secure Payments
Pre-Poured Agar Plates for Mycology
Our Pre-Poured Sorghum Agar plates are essential tools for mycologists, whether you’re germinating spores, isolating mycelium, or expanding your fungal cultures. Here’s what you need to know:
- Agar Medium: Agar is a nutritious gel that we’ve meticulously sterilized and poured into petri dishes. These agar plates are completely sterile, providing an ideal environment for rapid mycelial growth without contamination.
- Individually Sealed Plates: We understand the anxiety around contamination. That’s why we seal each agar plate individually. When you open the bag, you can be confident that your plates are protected until you’re ready to use them.
- Guaranteed Clean: Our commitment to quality means that every agar plate you receive is guaranteed to be sterile and free of contamination. If, by any rare chance, you encounter a contaminated plate, we’ll promptly replace it. Reach out to us via email or phone—we’re here to assist.
- Working with Agar Plates: Working with agar requires a sterile environment. You can create a simple still air box (SAB) using a clear tote with drilled arm holes. It’s a cost-effective way to minimize contamination risks.
- Shipping Details: Due to high demand, our Agar plates may take 24-48 hours before shipping, but most orders go out the next day.
Remember: Condensation during shipping is normal. The water in the agar may evaporate and condense on the plastic, but rest assured—the water itself remains sterile.
Feel free to explore our selection of Pre-Poured Agar plates and embark on your mycological journey! 🍄
| Quantity | 5, 10, 25, 50, 100 |
|---|---|
| Color | Natural, Black (Activated Carbon) |
You must be logged in to post a review.

Reviews
There are no reviews yet.